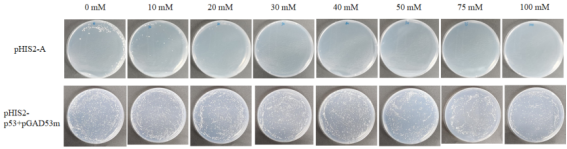
单杂3AT.jpg

酵母单杂原理介绍:体外分析DNA与细胞内蛋白质相互作用的一种方法。将已知特定顺式作用元件构建到最基本启动子上游,下游连接报告基因,通过对酵母细胞内报告基因表达状况的分析,来鉴别DNA结合位点并发现潜在的结合蛋白基因。

酵母文库构建
基本实验流程:RNA提取→cDNA文库构建
详细实验步骤:
①RNA提取 mRNA分离
②DNA合成与接头连接(三框库)
cDNA按长度分离 (均一化)
③重组到酵母单杂交载体pGADT7上和电转化
④文库检测和质粒提取
⑤数据整理和分析
酵母文库的质量指标
文库库容量>1*10^7CFU
平均插入片段0.8 - 1.5 kb (根据物种而定) 空载率<5%
交付材料
酵母文库甘油菌1.0ml EP管 (4管)
酵母文库质粒400ug
酵母工作菌液40ml
酵母单杂交文库筛选
基本实验流程:启动子背景筛查→文库筛选→回转验证
详细实验步骤:
①Binding seq基因启动子的背景筛查
②誘饵质粒转化和文库质粒转化
③酵母筛选和3AT条件优化
④筛选结果测序
⑤筛选结果回转验证
⑥数据整理和分析
交付材料
阳性克隆测序结果(≥25个)
Word文档电子版项目报告
酵母单杂交一对一验证
实验步骤:Binding seq基因启动子的背景筛查
一对一验证: pHis-A+pGADT7-B(实验组)
pHIS2-p53+pGADT7-53m(阳性对照)
pHIS2+pGADT7-53m(阴性对照)
服务特色:经验足 周期短 性价比高 通量高
客户提供
构建酵母文库材料
细胞样本:细胞数量>1*10^7 动物样本:>lg
植物样本:>2g 总RNA: >200μg
酵母单杂筛库材料
启动子序列 含有诱饵基因的质粒(可选)
酵母单杂交技术优点
1、无需分离纯化蛋白,实验简单易行
2、克服了体外研究时蛋白质通常处于非自然构象的缺点,因而具有很高的灵敏性。
酵母单杂交应用
1、检测已知DNA与蛋白之间是否存在相互作用;
2、分离编码结合于目的顺式调控元件或其他短DNA结合位点蛋白的新基因;
3、定位已经证实的具有相互作用的DNA结合蛋白的DNA结合结构域以及准确定位与DNA结合的核苷酸序列。
图片展示: